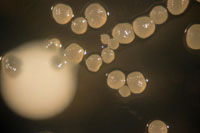

Establecer los niveles de riesgo de caries dental y entregar las pautas microbiológicas para aportar a un diagnóstico sobre infecciones del macizo bucomáxilo facial al cirujano dentista, son parte del quehacer que las TM. Profs. Nora Silva Steffens y Leyla Gómez Carranza, académicas del Departamento de Patología, desarrollan en el Laboratorio Clínico de Microbiología de la Facultad de Odontología de la Universidad de Chile.
Para restaurar la salud bucal deteriorada por diversos factores o prevenir futuras dolencias, la odontología moderna recibe hoy la contribución de otras disciplinas científicas que respaldan sus decisiones clínicas a la hora de atender a un paciente, de modo de poner al alcance del afectado soluciones integrales en salud oral.
Si bien los microorganismos no son los únicos responsables en el daño dental por la emergencia de caries, sino que es la conjunción de estos junto a los factores dietarios y la predisposición del hospedero, “investigar uno de ellos puede mejorar la situación del todo”, aseguró la TM Prof. Nora Silva.
Control de caries bajo la lupa
Tras obtener un Proyecto CONICYT en 1984, el Laboratorio de Microbiología inició sus estudios sobre Streptococcus mutans, microorganismo asociado a la etiología de caries. Mediante un trabajo de cuantificación de estos microorganismos en la saliva es posible determinar el nivel de riesgo de caries, siendo este indicador una potente herramienta en las labores de prevención y tratamiento de una de las enfermedades que afecta a un alto porcentaje de nuestra población.
“El Streptococcus mutans es habitante normal de la microbiota bucal, es decir, todos lo tenemos, pero hay niveles sobre los cuales se iniciaría el proceso de caries”, explicó la TM Prof. Leyla Gómez. La literatura odontológica internacional señala que el riesgo de que una persona desarrolle caries en un futuro próximo se encuentra en presentar sobre 1 x106 UFC (Unidades Formadoras de Colonias) de Streptococcus mutans por ml de saliva. Por lo que, conocer este recuento microbiológico, permite al odontólogo contar con un parámetro biológico más dentro de los involucrados en el proceso y, de este modo, poder tomar las medidas más adecuadas para atender a un paciente en particular.
Es así como en 1997 se oficializó, bajo la responsabilidad de la Prof. Silva, el funcionamiento del Laboratorio Clínico de Microbiología, el que se ubica en el tercer piso del Edificio de Investigación, Dr. Juan Colin. La unidad clínica constituye un servicio único en el país, puesto que cuenta con la competencia profesional y técnica calificada para ejecutar diagnósticos sobre la microbiología bucal, la que se caracteriza por su complejidad y comportamiento exclusivo de la cavidad oral.
La Unidad está equipada con los elementos técnicos e insumos necesarios para mantener en funcionamiento un Laboratorio Clínico de Microbiología Bucal, con las características del que posee nuestra Facultad.
Actualmente, el Área de Operatoria, de la Escuela de Pregrado y el Postítulo de Odontopediatría, en la Escuela de Graduados, utilizan los servicios del laboratorio. Específicamente, solicitan el recuento de S. mutans en saliva como parte del Protocolo de rutina, dentro de los exámenes solicitados a sus pacientes; esto como un marcador biológico que permite evaluar medidas de prevención así como las acciones odontológicas llevadas a cabo por sus alumnos. Además, el grupo de estudiantes de Postítulo reciben el sustento teórico y el entrenamiento práctico en el proceso de toma de muestras y análisis Microbiológico.
Del mismo modo, este laboratorio puede ser un valioso aporte para apoyar el diagnóstico de procesos infecciosos que afecten al territorio Bucomaxilo facial.
Identificando cándidas
Una afección común en pacientes que utilizan prótesis de acrílico, ya sea parciales o totales, son las candidiasis subprotésicas, infecciones provocadas por hongos que se desarrollan entre el aparato protésico y el paladar, puesto que la zona se transforma en una verdadera cámara de germinación generando lesiones y causando gran malestar a los adultos mayores que las padecen.
El Laboratorio Clínico de Microbiología ofrece el servicio de identificación de la especie de levadura asociada al proceso infeccioso subprotésico. De este modo, el cirujano dentista puede indicar el tratamiento antimicótico más adecuado para erradicar dicha infección.
Por la vigilancia microbiológica
La esterilización se define como la destrucción de todas las formas de microorganismos por su exposición a altas temperaturas en un tiempo prolongado. Este proceso permite que el instrumental médico-dental o de laboratorio, sometido a este procedimiento, se encuentre libre de microbios y pueda ser utilizado en procedimientos clínicos, sin riesgo de infecciones en el paciente.
Expuestas a altas temperaturas las bacterias mueren, sin embargo, existen ciertos géneros bacterianos que forman esporas, las que presentan gran resistencia. Si estas esporas no son destruidas y permanecen en el instrumental dental, por un proceso de esterilización inadecuado, y son introducidas en la cavidad bucal, el riesgo de originar una infección en una herida se multiplica, pues encuentran el ambiente adecuado, donde los microorganismos pueden nutrirse, reproducirse y multiplicarse.
La norma del Ministerio de Salud indica que todas las Clínicas Dentales deben realizar un Control Biológico de sus Centrales de Esterilización una vez al mes. Por lo que, en este sentido, estas unidades deben cumplir con dicha norma.
Los Controles Biológicos de Esterilización es otro de los servicios que ofrece el Laboratorio Clínico de Microbiología. Ellos se traducen en la validación del proceso de esterilización, a través de controles biológicos específicos.
El Laboratorio Clínico de Microbiología dirige este servicio a todas las Clínicas Dentales, públicas, privadas e institucionales del país. En la actualidad, mantiene una demanda estable desde la Escuela de Graduados de la Facultad de Odontología, el Ministerio de Vivienda, Servicios de podología y distintas empresas que venden equipos de esterilización a odontólogos y que certifican dichos equipos en el Laboratorio de la Facultad de Odontología.
Aplicando investigación
El Laboratorio Clínico de Microbiología soporta diversos Trabajos de Investigación, principalmente en Streptococcus mutans. Parte de ellos corresponden las Tesis para optar a Título de los estudiantes de Odontología. “En el fondo, vienen al Laboratorio a ratificar lo que tú le entregas en la clase teórica, durante su formación de Pregrado”, aclaró la TM Prof. Nora Silva.
Hoy día, la investigación realizada en el Laboratorio se dirige hacia una población de alto riesgo: los cardiópatas; para lo que están desarrollando Trabajos de Investigación con alumnos egresados de esta Facultad, para optar al Título de cirujano dentista, junto a un grupo de cardiólogos del Hospital Roberto del Río. “Existe una asociación, aún en estudio, entre algunos microbios de la cavidad bucal, más bien relacionados con la enfermedad periodontal e infarto al miocardio, placas de ateroma (placas grasas que se ubican en las arterias), y parto prematuro y bajo peso al nacer”, explicó la docente.
La literatura odontológica advierte que Streptococcus mutans “también es capaz de provocar agregación plaquetaria, es decir, forman trombos que pueden obstruir los vasos sanguíneos y dificultan la circulación sanguínea. Se ha observado que los microbios de la cavidad bucal pueden traspasar a la circulación y complejizar enfermedades de base como las cardiopatías, especialmente las congénitas, por lo que es fundamental la prevención”, expuso la TM Prof. Leyla Gómez.
En este contexto y en opinión de la Prof. Silva, el Laboratorio Clínico de Microbiología dicta norma en el área. “Hemos recibido solicitudes de entrenamiento e implementación de diferentes instituciones como el Laboratorio Clínico de de la Policía de Investigaciones, la Universidad de Antofagasta, e incluso del extranjero, como la Universidad de Buenos Aires y de Colombia, este ultimo país en lo que a estudio de S.mutans se refiere. quienes han reconocido la importancia de la microbiología y, por lo tanto, buscan replicar el Laboratorio en sus instalaciones”.
Asimismo, cabe distinguir que el Área de Microbiología imparte el Curso Anual para Asistentes Dentales, donde se les entrega un completo programa de estudios, enfocado a los aspectos microbiológicos que el asistente dental debe conocer y aplicar en su trabajo colaborativo con el profesional Cirujano dentista, especialmente en el Control Biológico, que es parte del trabajo cotidiano de la asistente dental en la Clínica. La Prof. Gómez destacó la demanda por la realización de este entrenamiento por parte de las asistentes dentales, “muchas de ellas vienen desde provincias, con un alto costo personal, viajando toda la noche para asistir al curso y luego retornar a sus lugares de trabajo para continuar sus labores. Ellas manifiestan gran entusiasmo y siempre se interesan en efectuar Controles de calidad en sus respectivas Clínicas, por lo que el Laboratorio está disponible para mantener este contacto”, finalizó la docente de la Facultad de Odontología.
|
Laboratorio clínico de microbiología Facultad de Odontología Universidad de Chile - Aranceles Control Biológico: a) Interno, Facultad de Odontología: $ 5.000, por muestra b) Externo, privados: $ 10.000, por muestra. Recuento de Streptococcus Mutans a) Interno, Facultad de Odontología: $ 3.800, por muestra b) Externo, privados: $ 7.000, por muestra. Cultivo y antibiograma de secreciones de la cavidad oral o de procesos infecciosos en general de la cavidad bucal. a) Interno, Facultad de Odontología: $ 4.500, por muestra b) Externo, privados: $6.000, por muestra. Contacto al teléfono: (56-2) 978 1791 |
Galería de fotos
Texto y Fotografías: Comunicaciones Facultad de Odontología